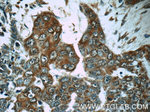
MMP28 Antibody in Immunohistochemistry (Paraffin) (IHC (P))
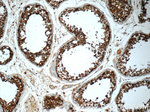
MMP28 Antibody in Immunohistochemistry (Paraffin) (IHC (P))

Search
Proteintech
MMP28 Polyclonal Antibody
{{$productOrderCtrl.translations['antibody.pdp.commerceCard.promotion.promotions']}}
{{$productOrderCtrl.translations['antibody.pdp.commerceCard.promotion.viewpromo']}}
{{$productOrderCtrl.translations['antibody.pdp.commerceCard.promotion.promocode']}}: {{promo.promoCode}} {{promo.promoTitle}} {{promo.promoDescription}}. {{$productOrderCtrl.translations['antibody.pdp.commerceCard.promotion.learnmore']}}
产品信息
18237-1-AP
种属反应
已发表种属
宿主/亚型
分类
类型
抗原
偶联物
形式
浓度
规格
纯化类型
保存液
内含物
保存条件
运输条件
产品详细信息
This antibody is specific to MMP28.
Immunogen sequence: LGNAFDGPG GALAHAFLPR RGEAHFDQDE RWSLSRRRGR NLFVVLAHEI GHTLGLTHSP APRALMAPYY KRLGRDALLS WDDVLAVQSL YGKPLGGSVA VQLPGKLFTD FETWDSYSPQ GRRPETQGPK YCHSSFDAIT VDRQQQLYIF KGSHFWEVAA DGNVSEPRPL QERWVGLPPN IEAAAVSLND GDFYFFKVQS V (194-393 aa encoded by BC002631)
靶标信息
Epilysin, also known as matrix metalloproteinase-28 (MMP-28), is a secreted protein that belongs to the peptidase M10A family. Matrix metalloproteinase proteins are responsible for the breakdown of the extracellular matrix which is important for normal physiological processes such as tissue remodeling, reproduction and embryonic development. Epilysin is produced by proliferating keratinocytes and is responsible for mediating the degradation of casein. Its expression is upregulated in response to injury of the skin suggesting that Epilysin may be involved in tissue repair and homeostasis. In addition, Epilysin may function predominantly in the nervous system. Incubation of Epilysin with rat embryonic brain tissue results in the degradation of myelin proteins. In Xenopus, Epilysin localizes to nerves and is upregulated during neurulation. This suggests that Epilysin plays an evolutionarily conserved role in neural development and may be involved in modulating the axonal-glial extracellular environment.
仅用于科研。不用于诊断过程。未经明确授权不得转售。
生物信息学
蛋白别名: Epilysin; matrix metallo protease; matrix metallopeptidase 28 (epilysin); matrix metalloprotease MMP25; matrix metalloproteinase 28 (epilysin); Matrix metalloproteinase-28; MMP; MMP-28; MMPs; neutral metalloproteinase; PRO4339; unnamed protein product; UNQ1893
基因别名: D130023P12; EPILYSIN; MM28; MMP-25; MMP-28; MMP25; MMP28; UNQ1893/PRO4339
UniProt ID: (Human) Q9H239
Entrez Gene ID: (Human) 79148, (Rat) 303384, (Mouse) 118453